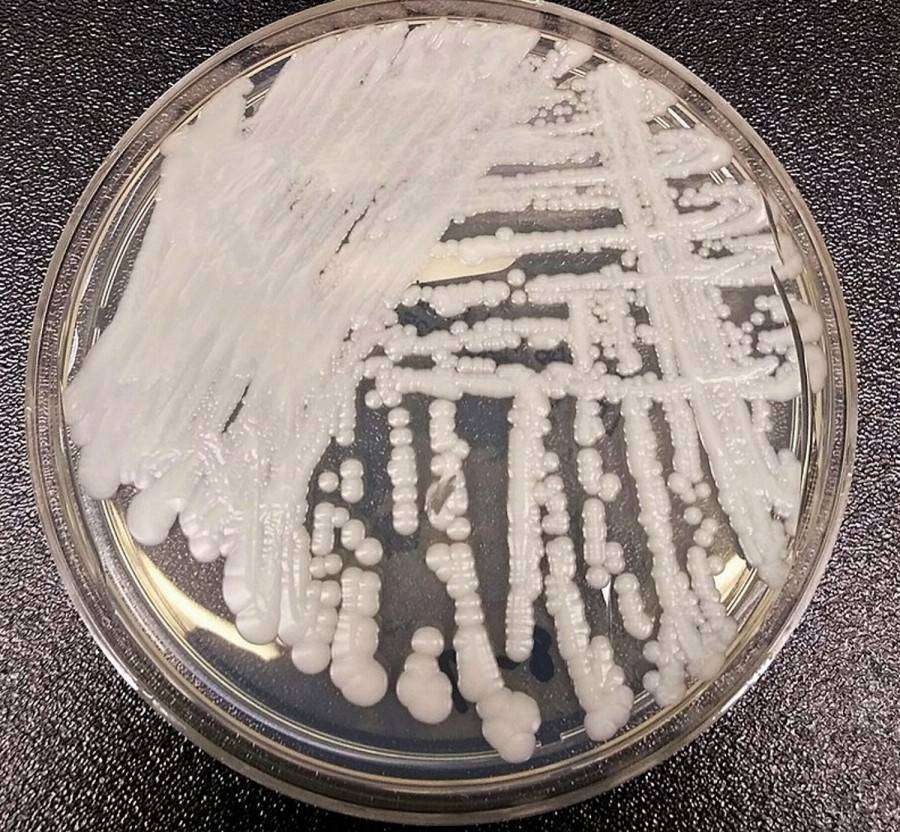
Candida Auris: Η νέα απειλή για την υγεία μας βρίσκεται μέσα στα νοσοκομεία

Τάσεις:
Livestreaming Η συνέντευξη Τύπου του Βασίλη Σπανούλη
–
Θεσσαλονίκη: Χειροπέδες σε 35χρονο Βούλγαρο για κατασκοπεία
–
Εξιτήριο για τον Γιώργο Μυλωνάκη από το κέντρο αποκατάστασης
–
Αδιανόητο δυστύχημα σε bungee jumping: Έριξαν 21χρονη στο κενό χωρίς να την δέσουν
–
Ανησυχία μετά τα 5,3 Ρίχτερ νότια της Μεθώνης